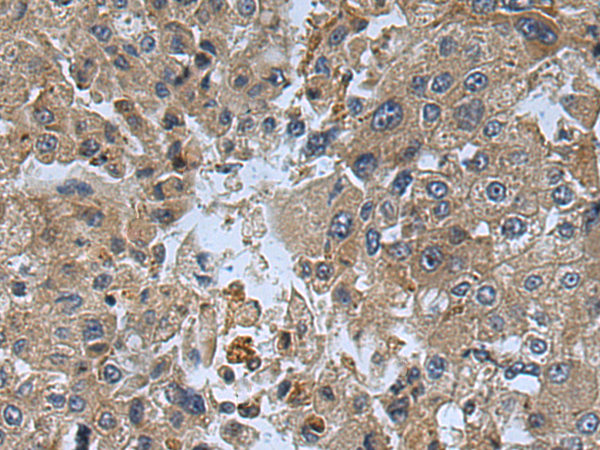
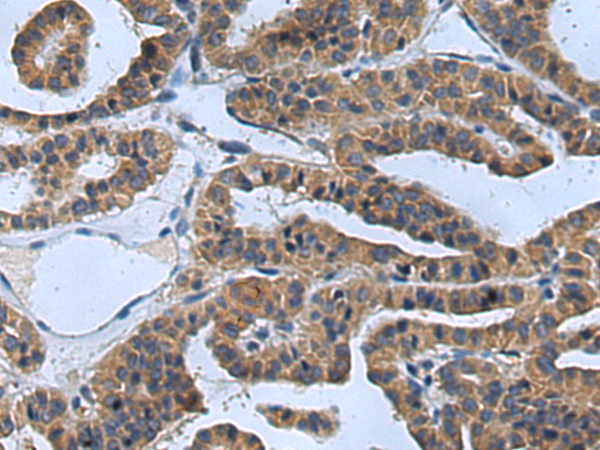

中文名稱: 兔抗TYK2多克隆抗體
|
Background: |
This gene encodes a member of the tyrosine kinase and, more specifically, the Janus kinases (JAKs) protein families. This protein associates with the cytoplasmic domain of type I and type II cytokine receptors and promulgate cytokine signals by phosphorylating receptor subunits. It is also component of both the type I and type III interferon signaling pathways. As such, it may play a role in anti-viral immunity. A mutation in this gene has been associated with hyperimmunoglobulin E syndrome (HIES) - a primary immunodeficiency characterized by elevated serum immunoglobulin E. |
|
Applications: |
ELISA, IHC |
|
Name of antibody: |
TYK2 |
|
Immunogen: |
Fusion protein of human TYK2 |
|
Full name: |
tyrosine kinase 2 |
|
Synonyms: |
JTK1; IMD35 |
|
SwissProt: |
P29597 |
|
ELISA Recommended dilution: |
5000-10000 |
|
IHC positive control: |
Human liver cancer and Human thyroid cancer |
|
IHC Recommend dilution: |
150-300 |

購物車
幫助
021-54845833/15800441009
